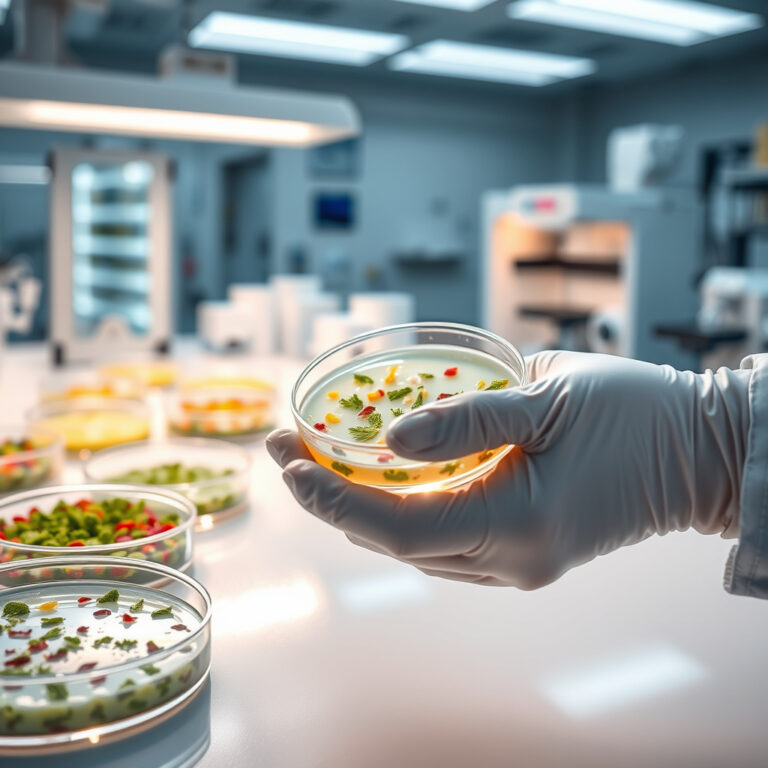

Automação em Laboratórios: O Futuro da Pesquisa e Análise é uma abordagem inovadora que utiliza tecnologias avançadas para otimizar processos laboratoriais, aumentando a eficiência, precisão e segurança nas pesquisas.
A Automação em Laboratórios: O Futuro da Pesquisa e Análise. é uma tendência que promete transformar a forma como os laboratórios operam.
Neste post, você descobrirá como a implementação de tecnologias de automação pode revolucionar a pesquisa e a análise em áreas como Química, Biologia e Análises Clínicas.
Prepare-se para explorar as vantagens, desafios e as inovações que estão moldando o futuro dos laboratórios!
Transformando Processos: O Papel da Automação na Pesquisa Científica
A pesquisa científica, um campo em constante evolução, busca não apenas respostas, mas também maneiras mais eficientes de obtê-las. A automação surge como uma aliada poderosa nesse contexto, transformando processos e permitindo que cientistas se concentrem em tarefas mais criativas e analíticas. No cenário atual, laboratórios estão adotando tecnologias que não apenas aceleram a execução de experimentos, mas também aumentam a precisão dos resultados.
A Eficiência dos Equipamentos Automatizados
Os Equipamentos de laboratório automatizados têm revolucionado a forma como as análises são conduzidas. Esses dispositivos, que vão desde pipetadores automáticos até sistemas de análise de dados, garantem que as etapas sejam realizadas com uma consistência que seria difícil de alcançar manualmente. Isso é especialmente crucial em áreas como biotecnologia e microbiologia, onde pequenos erros podem comprometer todo um experimento.
Integração de Reagentes e Materiais
A automação também facilita a integração de Reagentes químicos e outros Materiais para análises clínicas em um fluxo de trabalho contínuo. Com sistemas que gerenciam automaticamente a dosagem e o manuseio desses materiais, os pesquisadores podem reduzir o tempo gasto em tarefas repetitivas e minimizar o risco de contaminação. Isso não apenas melhora a segurança no laboratório, mas também assegura que os resultados sejam mais confiáveis.
Suprimentos para Laboratórios: Um Papel Fundamental
Outro aspecto importante da automação é a gestão eficiente dos Suprimentos para laboratórios. Com a implementação de sistemas automatizados para o controle de estoque, os laboratórios podem garantir que tenham sempre à disposição os materiais necessários para as suas pesquisas. Isso evita interrupções que podem atrasar projetos e, consequentemente, a inovação científica.
O Impacto na Pesquisa e Desenvolvimento
No presente, a automação está permitindo que laboratórios públicos e privados realizem pesquisas mais aprofundadas e abrangentes. A capacidade de processar grandes volumes de dados e realizar experimentos simultaneamente abre portas para descobertas que, de outra forma, poderiam levar anos para serem realizadas. Essa transformação é visível em diversos campos, incluindo a medicina, onde a análise rápida de amostras pode levar a diagnósticos precoces e tratamentos mais eficazes.
O Futuro da Automação em Laboratórios
À medida que a tecnologia avança, a tendência é que a automação se torne cada vez mais sofisticada. Os Produtos para laboratórios estão se tornando mais integrados, com sistemas que não apenas executam tarefas, mas também aprendem com as experiências anteriores. Isso promete uma nova era de eficiência e inovação na pesquisa científica, onde a colaboração entre humanos e máquinas levará a resultados ainda mais surpreendentes.
Integração de Sistemas: A Chave para Laboratórios Modernos
O Que É Integração de Sistemas?
A integração de sistemas refere-se à conexão de diferentes plataformas e tecnologias que um laboratório utiliza para otimizar suas operações. Nos dias de hoje, a variedade de Produtos para laboratórios, equipamentos e softwares disponíveis pode ser avassaladora. Através da integração, é possível criar um fluxo de trabalho contínuo, onde dados e informações circulam de forma eficiente entre diferentes departamentos e equipamentos, minimizando erros e aumentando a produtividade.
A Importância da Integração para a Automação
A automação em laboratórios está transformando a forma como a pesquisa e análises são realizadas. Com a integração de sistemas, é possível automatizar processos que antes eram manuais, como a coleta e análise de dados. Equipamentos de biologia molecular e instrumentos de microbiologia podem ser conectados a softwares que gerenciam todo o processo, desde a preparação de amostras até a geração de relatórios. Isso não apenas economiza tempo, mas também melhora a precisão dos resultados.
Benefícios da Integração de Sistemas
A integração de sistemas em laboratórios oferece uma série de benefícios que são cruciais para o sucesso das operações. Dentre eles, podemos destacar:
- Aumento da Eficiência: Fluxos de trabalho mais rápidos com menos interrupções.
- Redução de Erros: Menos chances de erro humano na entrada de dados e na manipulação de informações.
- Melhoria na Comunicação: Compartilhamento de informações em tempo real entre equipes e equipamentos.
- Otimização de Recursos: Uso mais eficiente de equipamentos e suprimentos para laboratórios.
Como Implementar a Integração em Laboratórios
Para implementar a integração de sistemas, é fundamental seguir algumas etapas. Primeiro, é necessário avaliar quais equipamentos e softwares estão em uso e como eles se comunicam entre si. Em seguida, é importante escolher plataformas que sejam compatíveis e que ofereçam APIs ou outras formas de integração. Por exemplo, equipamentos de laboratório podem ser conectados a sistemas de gerenciamento de dados, permitindo que análises sejam realizadas de maneira mais fluida.
Além disso, deve-se considerar a formação da equipe. É essencial que os colaboradores saibam como utilizar a nova tecnologia e como aproveitar ao máximo as funcionalidades oferecidas. A capacitação é um passo fundamental para garantir que a automação em laboratórios se torne uma realidade eficaz.
O Futuro da Integração em Laboratórios
No presente, a tendência é que a integração de sistemas continue a se expandir, trazendo novas possibilidades para laboratórios públicos e privados. À medida que a tecnologia avança, novas soluções de automação surgem, permitindo que laboratórios adotem práticas mais ágeis e inovadoras. A utilização de reagentes químicos e materiais para análises clínicas se tornará ainda mais eficiente, uma vez que a integração permitirá um controle de qualidade superior e uma gestão mais eficaz dos consumíveis de laboratório.
A integração de sistemas não é apenas uma opção, mas uma necessidade para laboratórios que desejam se manter competitivos e relevantes no cenário atual. Com uma abordagem cuidadosa e bem planejada, é possível transformar a rotina laboratorial, tornando-a mais dinâmica e alinhada com as demandas contemporâneas da pesquisa científica.
Desafios e Oportunidades: Implementando Automação em Laboratórios
A implementação da automação em laboratórios é um passo significativo que traz tanto desafios quanto oportunidades. No cenário atual, muitos profissionais enfrentam a resistência à mudança, principalmente por parte de equipes que estão habituadas a processos tradicionais. Essa resistência pode ser um dos principais obstáculos, mas, ao mesmo tempo, representa uma oportunidade de reeducação e aprimoramento das habilidades dos colaboradores. A formação contínua e a transparência sobre os benefícios da automação podem ajudar a suavizar essa transição.
Desafios na Implementação
- Integração de Sistemas: A harmonização dos novos equipamentos com sistemas existentes pode ser complexa. É crucial que os laboratórios realizem uma análise detalhada das necessidades antes de adquirir novos equipamentos de laboratório.
- Custo Inicial: O investimento inicial em tecnologia automatizada pode ser alto. No entanto, é importante considerar a economia a longo prazo, como a redução de erros e o aumento da eficiência.
- Treinamento de Equipe: A capacitação dos colaboradores é essencial. A falta de familiaridade com novos sistemas pode resultar em subutilização da tecnologia, portanto, investir em treinamento é fundamental.
Oportunidades que a Automação Oferece
- Aumento da Eficiência: Processos automatizados podem acelerar a realização de análises, permitindo que os laboratórios atendam a demanda crescente por resultados rápidos.
- Precisão e Repetibilidade: A automação reduz a margem de erro humano, garantindo que os resultados sejam consistentes e confiáveis. Isso é crucial, especialmente em laboratórios de análises clínicas, onde a precisão é vital.
- Melhoria na Gestão de Dados: Sistemas automatizados facilitam a coleta e o gerenciamento de dados, permitindo que pesquisadores e técnicos trabalhem com informações mais organizadas e acessíveis.
- Inovação em Pesquisa: A automação libera os profissionais para se concentrarem em atividades de maior valor, como pesquisa e desenvolvimento, levando a descobertas inovadoras.
Além disso, a automação pode potencializar o uso de produtos para laboratórios, como reagentes químicos e consumíveis. Com a implementação correta, a integração de novos equipamentos de biologia molecular e instrumentos de microbiologia se torna mais fluida, permitindo um fluxo de trabalho mais ágil e produtivo. Num laboratório, a adoção de tecnologias automatizadas não é apenas uma tendência; é uma realidade que transforma a maneira como as análises são conduzidas e os resultados são interpretados.
O Futuro das Análises Clínicas com Automação Avançada
No cenário atual das análises clínicas, a automação avançada está se tornando uma aliada essencial para aprimorar a precisão e a eficiência dos laboratórios. Em um mundo onde a demanda por resultados rápidos e confiáveis cresce a cada dia, a integração de tecnologias automatizadas promete transformar radicalmente o modo como os testes e diagnósticos são realizados.
Aumentando a Eficiência Operacional
Com a implementação de sistemas automatizados, laboratórios de análises clínicas podem otimizar seus processos, reduzindo o tempo necessário para a realização de exames complexos. A automação permite que equipamentos de laboratório realizem tarefas repetitivas, minimizando a intervenção humana e, consequentemente, os erros associados. A utilização de robôs e softwares especializados torna-se crucial, especialmente em ambientes de alta demanda, onde a velocidade e a precisão são fundamentais.
Qualidade dos Resultados e Redução de Custos
Outro benefício significativo da automação é a melhoria na qualidade dos resultados. Sistemas automatizados são projetados para operar com precisão, o que se traduz em diagnósticos mais confiáveis. Além disso, a automação ajuda a reduzir custos operacionais, permitindo que laboratórios públicos e privados utilizem seus materiais para análises clínicas de forma mais eficiente. Isso, por sua vez, pode resultar em uma diminuição dos preços dos exames para os pacientes.
Integração de Tecnologias Inovadoras
A automação em laboratórios não se limita apenas à utilização de equipamentos. Envolve também a integração de diferentes tecnologias, como inteligência artificial e aprendizado de máquina, para analisar dados de forma mais eficaz. Essa integração permite que os laboratórios identifiquem padrões e tendências que, de outra forma, poderiam passar despercebidos. A análise preditiva, por exemplo, pode dar insights valiosos sobre a saúde da população, facilitando a tomada de decisões em saúde pública.
Desafios da Implementação
Embora os benefícios sejam numerosos, a implementação da automação em laboratórios também apresenta desafios. A necessidade de formação contínua para os profissionais que operam produtos para laboratórios e equipamentos avançados é um fator a ser considerado. Além disso, a resistência à mudança e a adaptação a novas tecnologias podem ser barreiras que precisam ser superadas para que a automação seja efetiva. O investimento inicial em tecnologia, embora possa ser elevado, é um passo necessário para colher os frutos a longo prazo.
Olhando para o Futuro
O futuro das análises clínicas está intrinsecamente ligado à evolução da automação. À medida que novas tecnologias de biotecnologia e inovação em reagentes químicos continuam a surgir, espera-se que os laboratórios se tornem cada vez mais eficientes e precisos. A automação não é apenas uma tendência passageira; é uma revolução que está moldando o futuro da pesquisa e análise no campo da saúde. Esse caminho promissor levanta a expectativa de que, em breve, poderemos contar com diagnósticos ainda mais rápidos e eficazes, beneficiando tanto os profissionais de saúde quanto os pacientes.
Capacitação Profissional: Preparando-se para a Era da Automação
O Novo Cenário da Automação em Laboratórios
No cenário atual, a automação em laboratórios tem se mostrado uma ferramenta essencial para otimizar processos e aumentar a eficiência nas análises. Com o avanço tecnológico, é fundamental que os profissionais da área busquem constantemente a capacitação para se adaptar a essas mudanças. A automação não apenas transforma a forma como os laboratórios operam, mas também redefine as competências necessárias para os especialistas que atuam nesse ambiente.
A Importância da Capacitação Contínua
A capacitação contínua é vital para que os profissionais estejam alinhados com as novas tecnologias e metodologias. Programas de treinamento que enfoquem o uso de equipamentos de laboratório, softwares de gestão e análise de dados são essenciais. Além disso, a compreensão de como integrar diferentes materiais para análises clínicas e reagentes químicos com as novas plataformas automatizadas é um diferencial significativo. Assim, os profissionais tornam-se mais versáteis e preparados para enfrentar os desafios do dia a dia.
- Treinamentos práticos em automação de processos
- Atualização sobre novos produtos para laboratórios
- Desenvolvimento de habilidades em análise de dados
Desenvolvendo Habilidades Técnicas e Humanas
Além das habilidades técnicas, as competências interpessoais também são fundamentais. A capacidade de trabalhar em equipe, comunicação eficaz e resolução de problemas são habilidades que complementam a formação técnica. Profissionais que conseguem articular suas competências técnicas com uma boa comunicação se destacam em ambientes colaborativos, onde a integração de sistemas é imprescindível.
Oportunidades no Mercado de Trabalho
À medida que os laboratórios adotam soluções automatizadas, a demanda por profissionais qualificados cresce. Oportunidades em laboratórios públicos e privados estão se expandindo, e aqueles que se preparam adequadamente têm mais chances de se destacar. A especialização em áreas como biotecnologia, microbiologia e análise de dados se torna um ativo valioso neste novo cenário.
Preparando-se para o Futuro
Os profissionais que buscam se capacitar devem estar atentos às inovações que surgem constantemente. A automação em laboratórios não é apenas uma tendência passageira, mas sim uma mudança de paradigma que moldará o futuro das análises clínicas. Investir em educação e formação continuada é, portanto, um passo essencial para quem deseja permanecer relevante e competitivo no mercado.
Ao se preparar para essa nova era, os profissionais não apenas garantem seu lugar no mercado de trabalho, mas também contribuem para a evolução dos processos laboratoriais, tornando-os mais rápidos, precisos e eficientes. Com isso, a capacitação profissional se torna um elemento chave na construção de um futuro promissor para a área de automação em laboratórios.
Tendências Futuras: O Que Esperar da Automação em Laboratórios
Nos dias de hoje, a automação em laboratórios está se consolidando como uma verdadeira revolução no modo como a pesquisa e a análise são conduzidas. A integração de tecnologias avançadas está permitindo que os profissionais do setor realizem tarefas com mais eficiência e precisão, criando um ambiente propício para inovações. À medida que essa transformação acontece, é essencial entender as tendências que moldarão o futuro dos laboratórios.
Integração de Inteligência Artificial e Machine Learning
A incorporação da inteligência artificial (IA) e do machine learning nos laboratórios é uma tendência crescente. Esses sistemas são capazes de analisar grandes volumes de dados, identificando padrões que podem passar despercebidos por análises humanas. Isso não só otimiza o tempo, mas também aumenta a confiabilidade dos resultados. Com a automação, a utilização de produtos para laboratórios que suportam essas tecnologias se torna uma necessidade, garantindo que os procedimentos sejam realizados com a máxima eficácia.
Análise em Tempo Real
A automação também está permitindo que análises sejam realizadas em tempo real. Isso é especialmente importante em áreas como análises clínicas, onde a rapidez e a precisão dos resultados podem impactar diretamente diagnósticos e tratamentos. Equipamentos de laboratório modernos estão sendo desenvolvidos para fornecer dados instantâneos, facilitando a tomada de decisões rápidas e informadas. Essa tendência pode transformar o ambiente dos laboratórios públicos e privados, elevando os padrões de atendimento.
Customização e Flexibilidade
Outra tendência significativa é a customização dos sistemas de automação. Os laboratórios estão buscando soluções que possam ser adaptadas às suas necessidades específicas. Isso inclui a escolha de materiais para análises clínicas que se alinhem com os processos já existentes. A flexibilidade dos sistemas automatizados possibilita que as instituições ajustem suas operações, garantindo que estejam sempre atualizadas com as melhores práticas do setor.
Capacitação e Treinamento Contínuo
À medida que a automação avança, a capacitação profissional se torna crucial. Os colaboradores precisam estar preparados para lidar com novas tecnologias e equipamentos. Programas de formação e workshops são fundamentais para garantir que as equipes entendam como tirar o máximo proveito dos novos sistemas. Isso não apenas melhora a eficiência, mas também cria um ambiente de trabalho mais colaborativo e inovador.
Sustentabilidade e Eficiência Energética
A preocupação com a sustentabilidade é uma tendência cada vez mais presente. Laboratórios estão buscando soluções que minimizem o desperdício e aumentem a eficiência energética. A automação pode contribuir significativamente para esses objetivos, permitindo um uso mais racional de reagentes químicos e suprimentos. Com equipamentos mais eficientes, os laboratórios podem reduzir sua pegada ambiental enquanto mantêm a qualidade das análises.
Desenvolvimento de Produtos Inovadores
Por fim, a automação em laboratórios está impulsionando o desenvolvimento de novos produtos de biotecnologia e equipamentos de laboratório. As inovações estão surgindo a partir da necessidade de soluções que atendam às demandas crescentes do mercado, criando um ciclo de melhorias contínuas. Isso beneficia não apenas os laboratórios, mas também a sociedade como um todo, ao possibilitar descobertas científicas que podem transformar a vida das pessoas.
As tendências atuais mostram um futuro promissor para a automação em laboratórios, onde a tecnologia não apenas melhora a eficiência, mas também amplia as possibilidades de pesquisa e análise. Com um olhar atento para essas inovações, os profissionais da área podem se preparar para um horizonte repleto de oportunidades e avanços significativos.